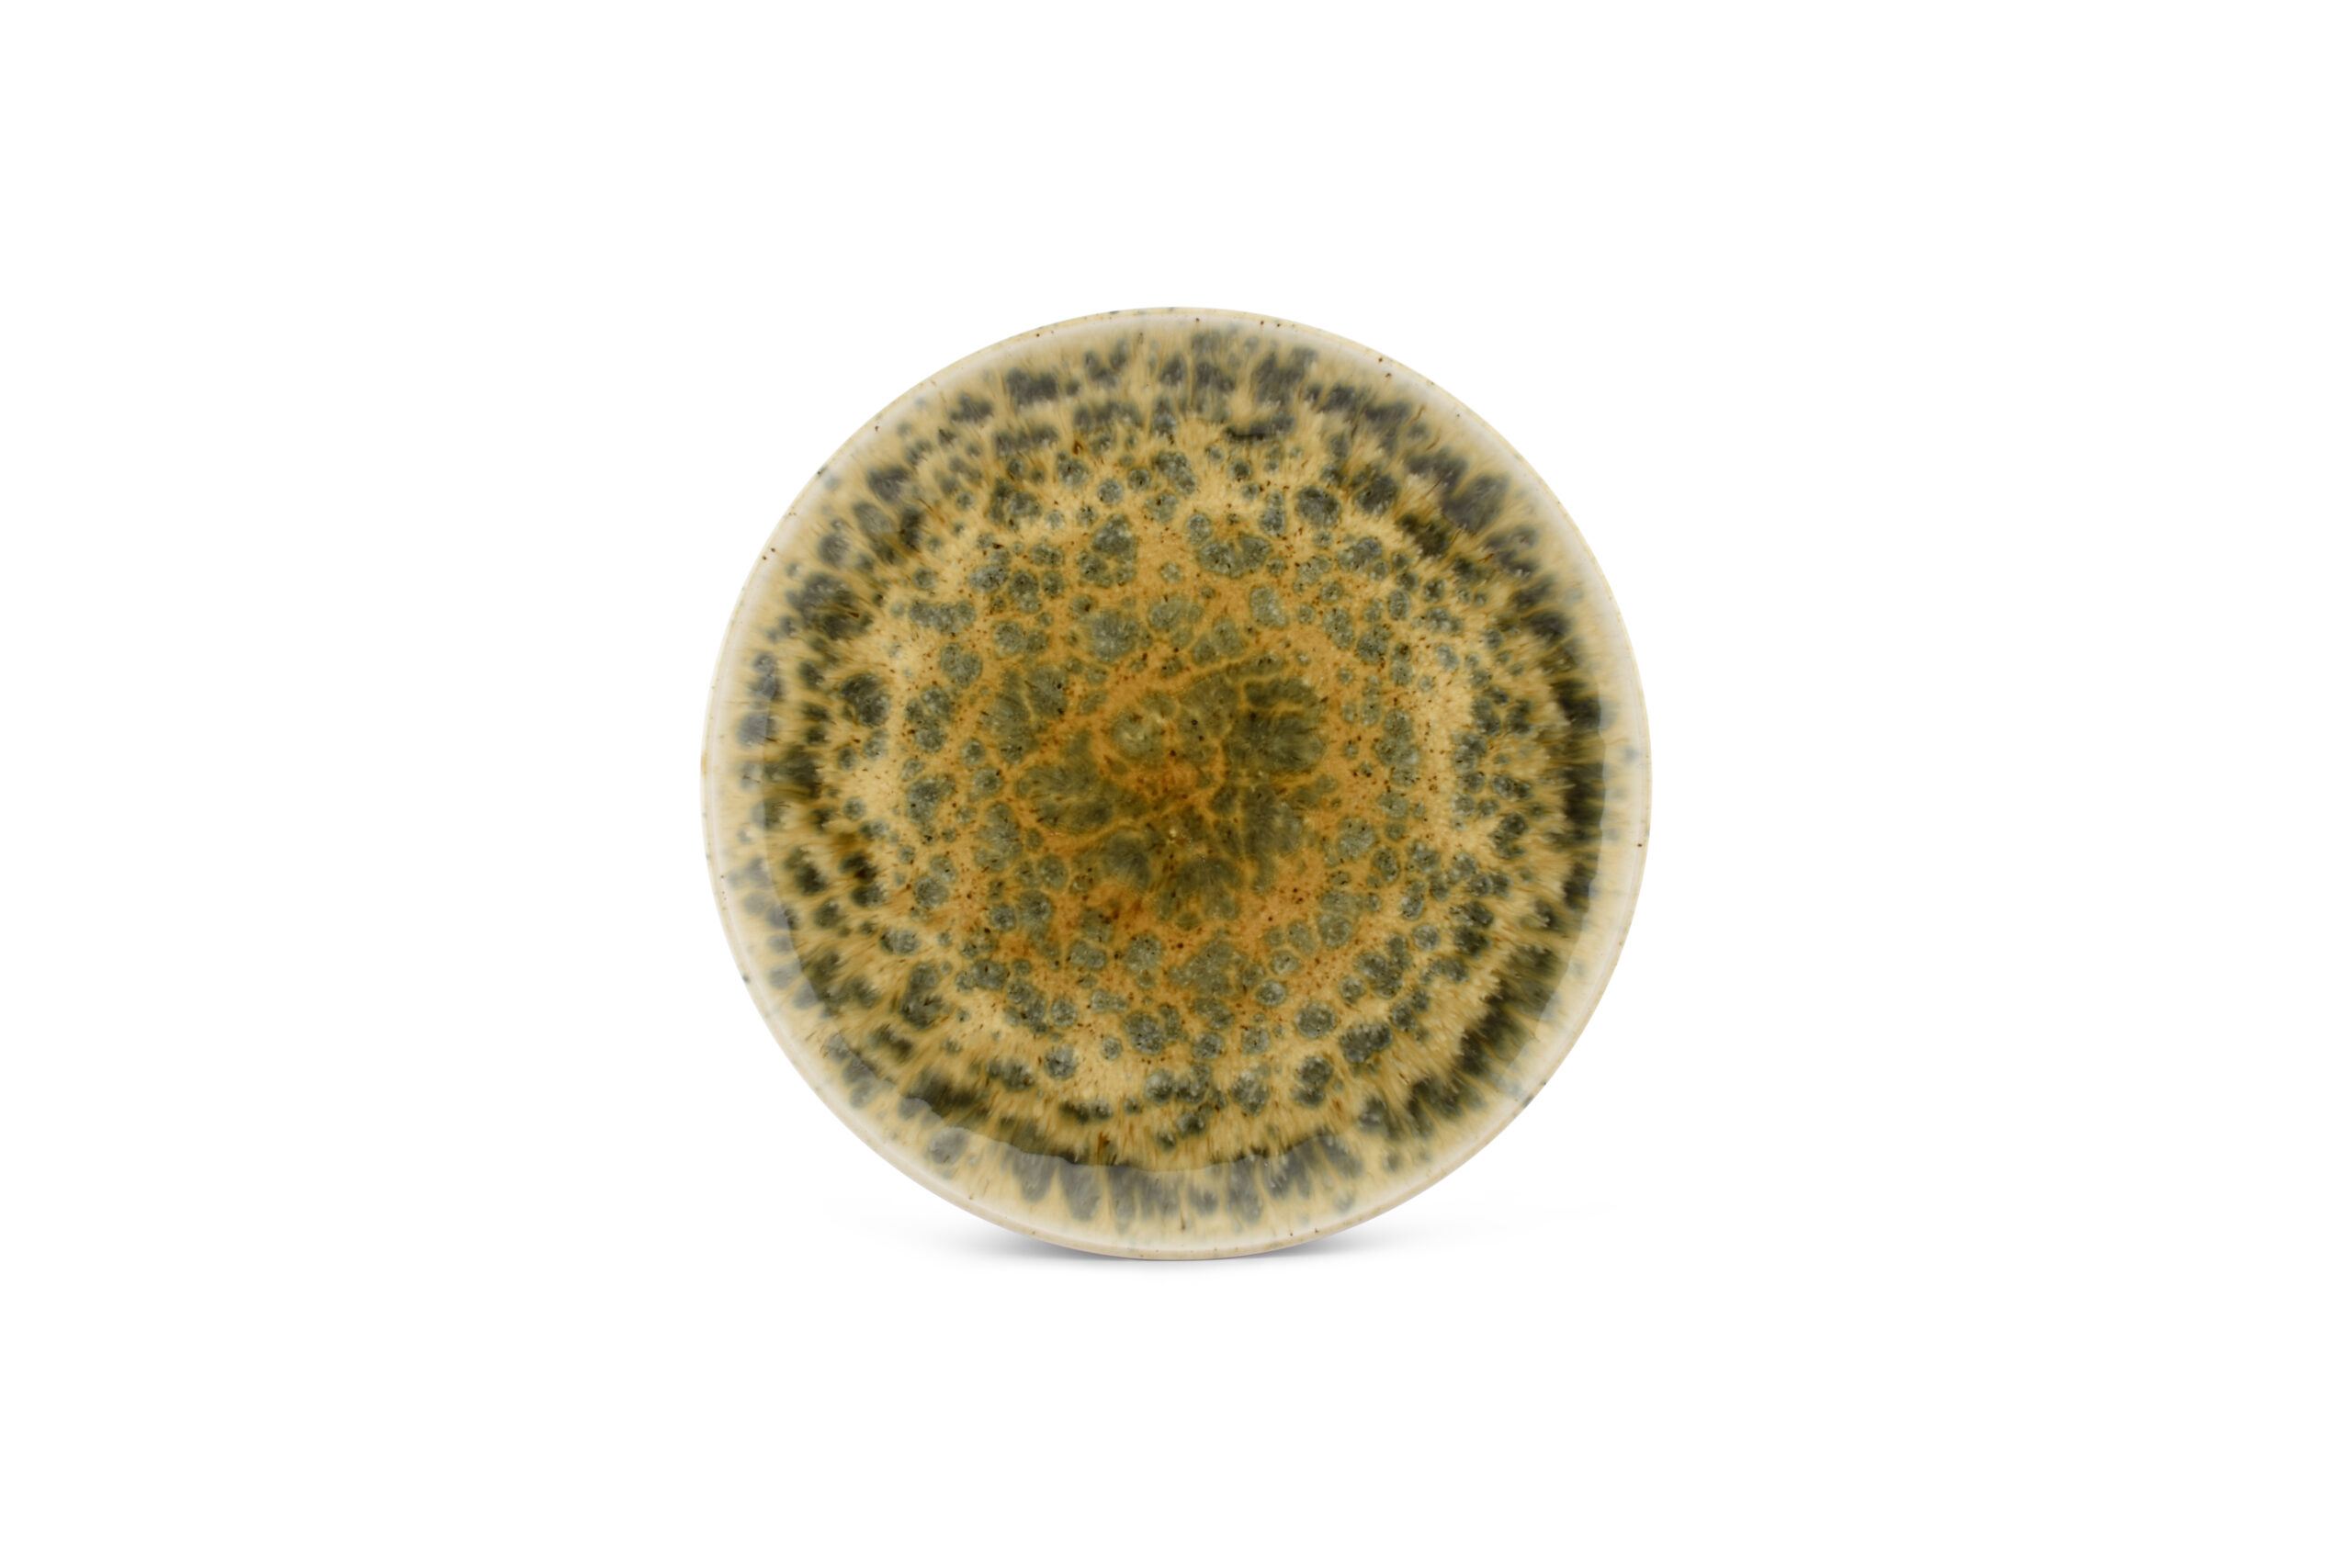

Recent toegevoegde item(s)
Aanbieding!
Plat bord 30cm groenbruin Resto
€ 13,95 Oorspronkelijke prijs was: € 13,95.€ 11,16Huidige prijs is: € 11,16.
Plat bord 30cm groenbruin Resto
Categorieën: Borden, Resto serie
Beschrijving
Plat bord 30cm groenbruin Resto
Wees de eerste om “Plat bord 30cm groenbruin Resto” te beoordelen Reactie annuleren
Gerelateerde producten
-
€ 4,95Oorspronkelijke prijs was: € 4,95.€ 3,96Huidige prijs is: € 3,96. -
€ 11,95Oorspronkelijke prijs was: € 11,95.€ 9,56Huidige prijs is: € 9,56. -
€ 4,50Oorspronkelijke prijs was: € 4,50.€ 3,60Huidige prijs is: € 3,60. -
€ 14,95Oorspronkelijke prijs was: € 14,95.€ 11,96Huidige prijs is: € 11,96.

Beoordelingen
Er zijn nog geen beoordelingen.